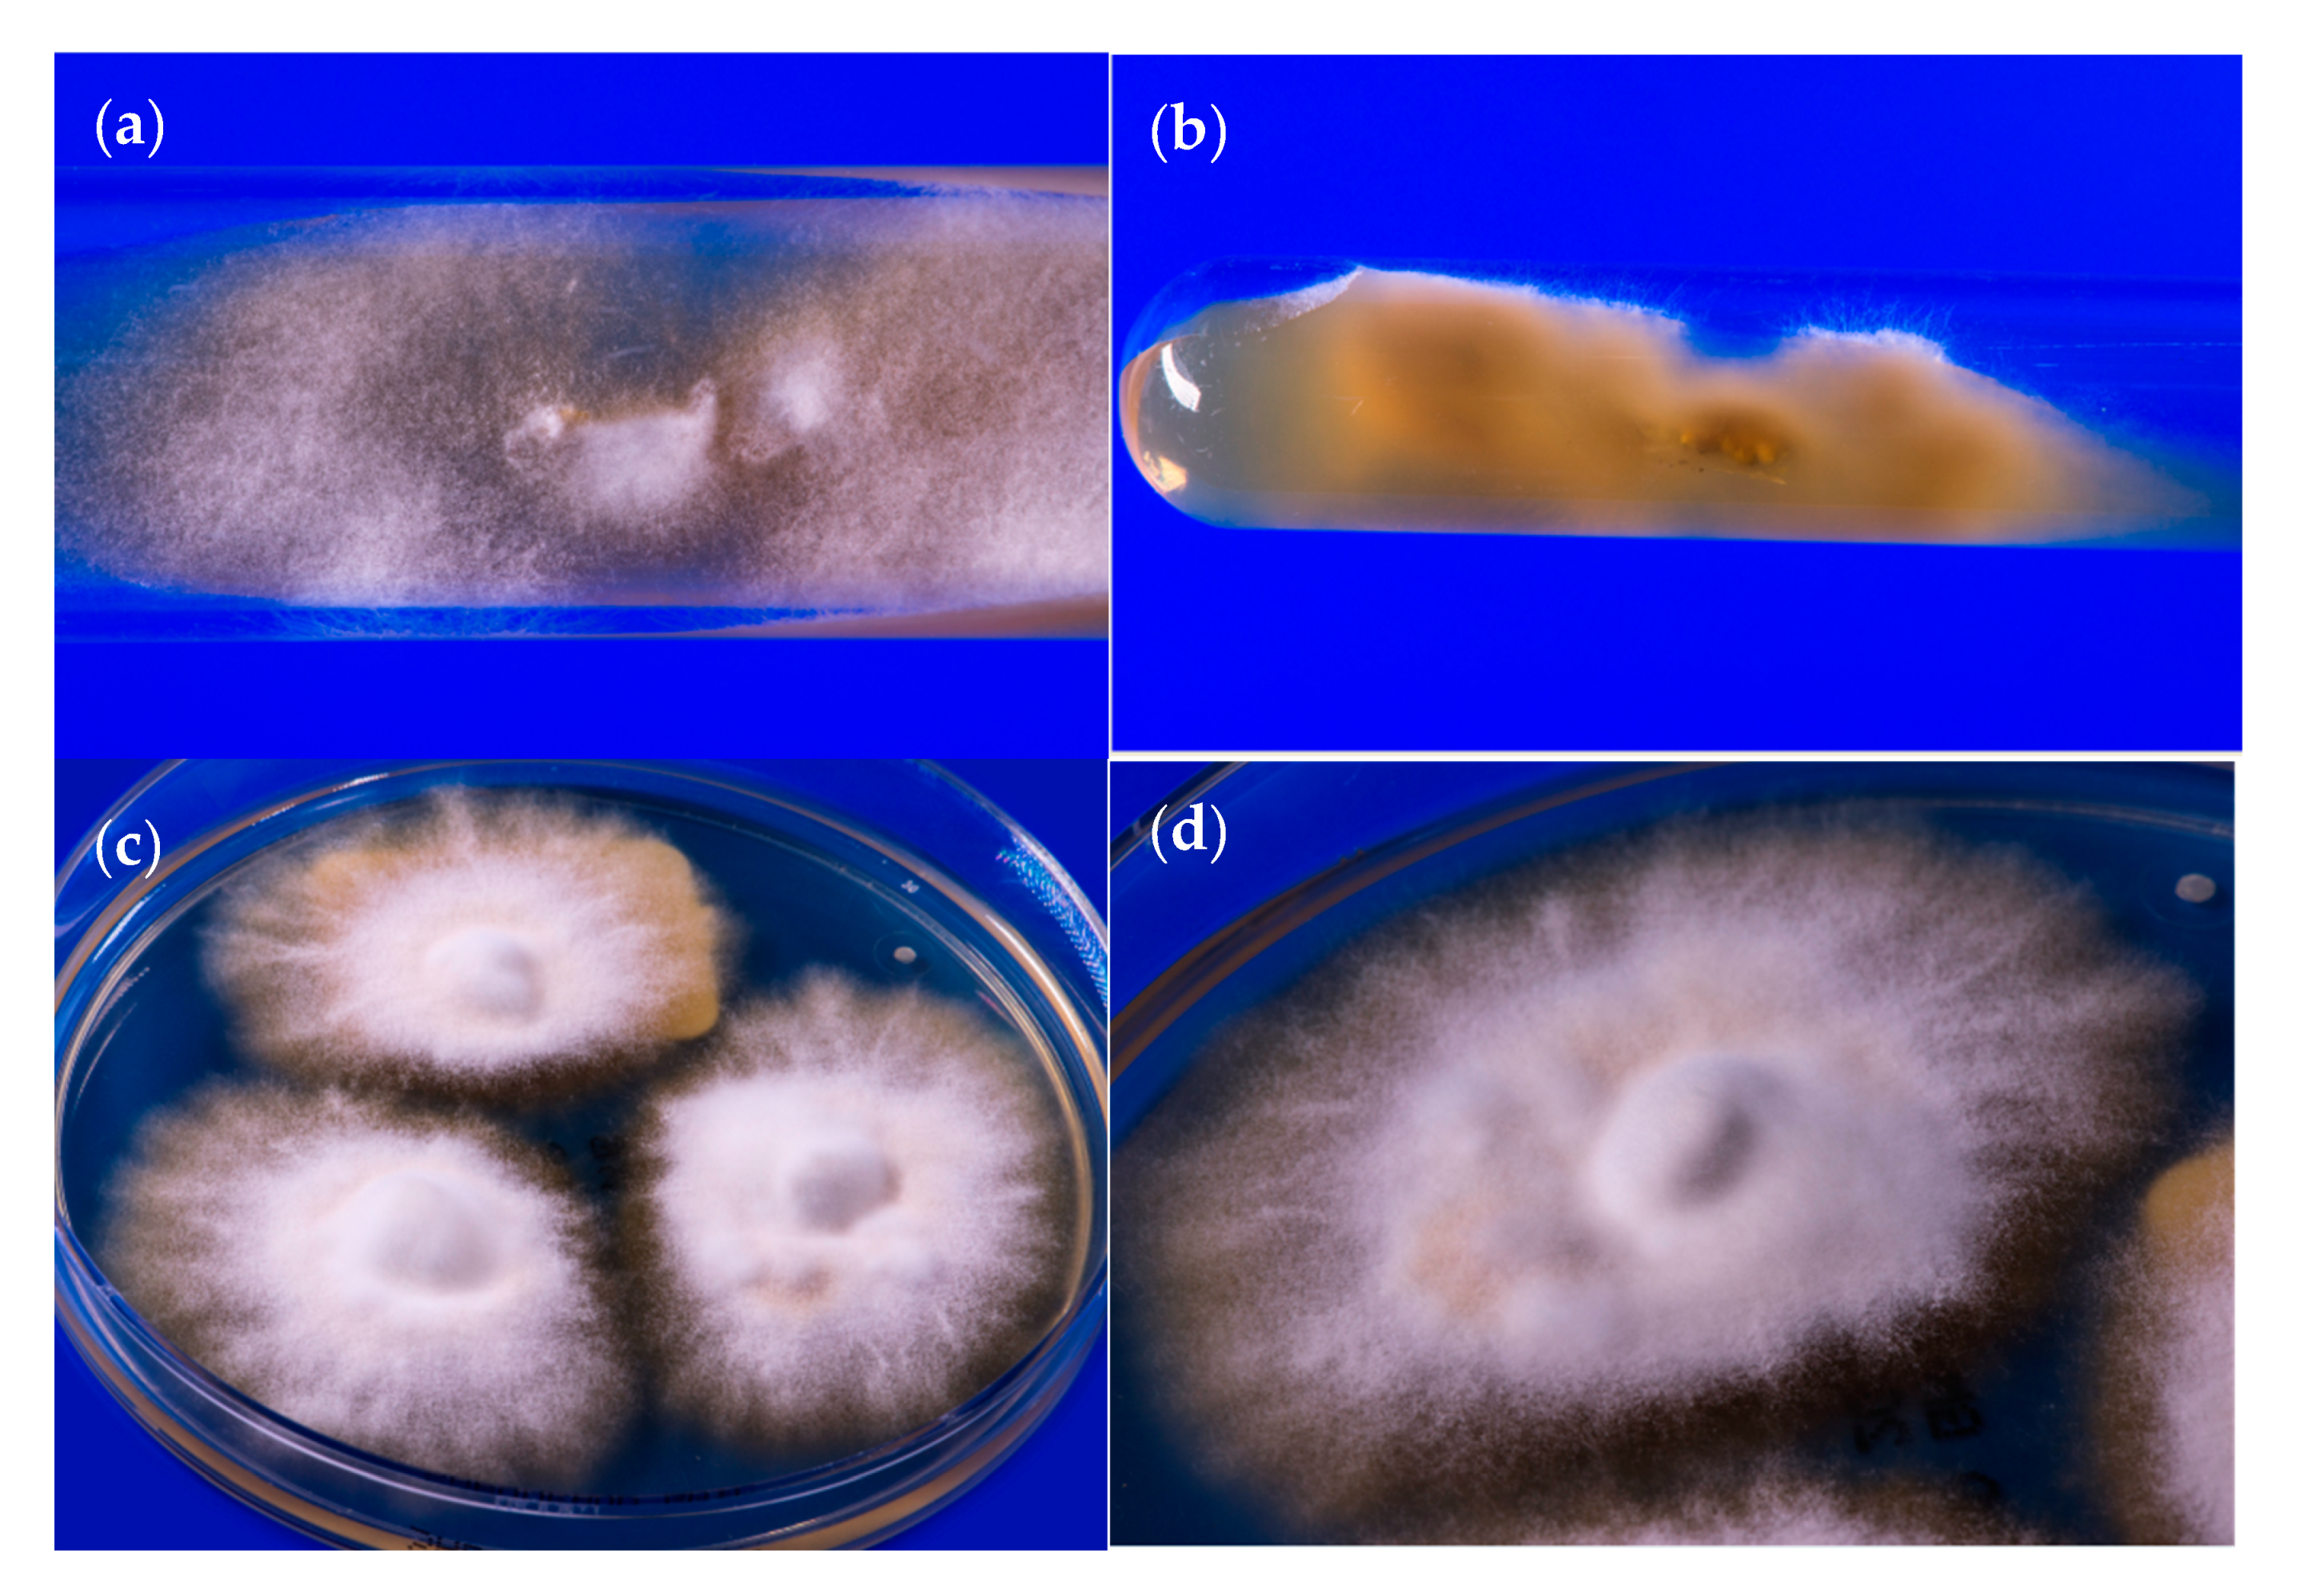
Jof 06 00207 g005 Jof 06 00207 g005

Spread of Terbinafine-Resistant Trichophyton mentagrophytes Type VIII (India) in Germany–“The Tip of the Iceberg?”
Abstract
1. Introduction
2. Patients and Methods
2.1. Patients
2.2. Conventional Cultural Diagnostics
2.3. Molecular Biological Characteristics of Trichophyton mentagrophytes ITS Type VIII
2.3.1. PCR-ELISA for Molecular Identification of Dermatophytes
2.3.2. Sequencing of the ITS Regions of rDNA Genes for Species Identification of Trichophyton mentagrophytes Type VIII
2.3.3. Phylogenetic Analysis of Trichophyton mentagrophytes Type VIII
2.3.4. Statistical Method for Generating Phylogenetic Trees
2.3.5. Deposition of the Isolates in Strain Collections and Gene Databases
2.4. Antifungal Resistance Testing
2.4.1. In Vitro Antifungal Susceptibility Testing
2.4.2. Squalene Epoxidase Gene Analysis
3. Results
3.1. Patients
3.2. Some Striking Clinical Presentations
3.3. Antifungal Resistance Testing and Point Mutation Analysis
4. Discussion
4.1. Trichophyton mentagrophytes Type VIII (India)
4.2. Spread of T. mentagrophytes Type VIII (India) to Other Parts of the World
4.3. Antifungal Resistance In Vitro and Point Mutation Analysis of the Squalene Epoxidase Gene
4.4. Treatment of Chronic Recalcitrant Dermatophytoses Due to T. mentagrophytes Type VIII
Author Contributions
Funding
Acknowledgments
Conflicts of Interest
References
- Verma, S.B.; Madhu, R. The great Indian epidemic of superficial dermatophytosis: An appraisal. Indian J. Dermatol. 2017, 62, 227–236. [Google Scholar] [CrossRef]
- Verma, S.; Vasani, R.; Reszke, R.; Matusiak, Ł.; Szepietowski, J.C. Prevalence and clinical characteristics of itch in epidemic-like scenario of dermatophytoses in India: A cross-sectional study. J. Eur. Acad Dermatol. Venereol. 2020, 34, 180–183. [Google Scholar] [CrossRef]
- Verma, S.B. Comment on: Emergence of recalcitrant dermatophytosis in India. Lancet Infect. Dis. 2018, 18, 718–719. [Google Scholar] [CrossRef]
- Winter, I.; Uhrlaß, S.; Krüger, C.; Herrmann, J.; Bezold, G.; Winter, A.; Barth, S.; Simon, J.C.; Gräser, Y.; Nenoff, P. Molecular biological detection of dermatophytes in clinical samples when onychomycosis or tinea pedis is suspected. A prospective study comparing conventional dermatomycological diagnostics and polymerase chain reaction. Hautarzt 2013, 64, 283–289. [Google Scholar] [CrossRef] [PubMed]
- Beifuss, B.; Bezold, G.; Gottlöber, P.; Borelli, C.; Wagener, J.; Schaller, M.; Korting, H.C. Direct detection of five common dermatophyte species in clinical samples using a rapid and sensitive 24-h PCR-ELISA technique open to protocol transfer. Mycoses 2011, 54, 137–145. [Google Scholar] [CrossRef] [PubMed]
- Mirhendi, H.; Makimura, K.; De Hoog, G.S.; Rezaei-Matehkolaei, A.; Najafzadeh, M.J.; Umeda, Y.; Ahmadi, B. Translation elongation factor 1-α gene as a potential taxonomic and identification marker in dermatophytes. Med. Mycol. 2015, 53, 215–224. [Google Scholar] [CrossRef] [PubMed]
- Kargl, A.; Kosse, B.; Uhrlaß, S.; Koch, D.; Krüger, C.; Eckert, K.; Nenoff, P. Hedgehog fungi in a dermatological office in Munich: Case reports and review. Hautarzt 2018, 69, 576–585. [Google Scholar] [CrossRef] [PubMed]
- Uhrlaß, S.; Schroedl, W.; Mehlhorn, C.; Krüger, C.; Hubka, V.; Maier, T.; Gräser, Y.; Paasch, U.; Nenoff, P. Molecular epidemiology of Trichophyton quinckeanum-a zoophilic dermatophyte on the rise. J. Dtsch. Dermatol. Ges. 2018, 16, 21–32. [Google Scholar] [CrossRef] [PubMed]
- Wiegand, C.; Mugisha, P.; Mulyowa, G.K.; Elsner, P.; Hipler, U.-C.; Gräser, Y.; Uhrlaß, S.; Nenoff, P. Identification of the causative dermatophyte of tinea capitis in children attending Mbarara Regional Referral Hospital in Uganda by PCR-ELISA and comparison with conventional mycological diagnostic methods. Med. Mycol. 2017, 55, 660–668. [Google Scholar] [CrossRef]
- Tamura, K.; Nei, M. Estimation of the number of nucleotide substitutions in the control region of mitochondrial DNA in humans and chimpanzees. Mol. Biol. Evol. 1993, 10, 512–526. [Google Scholar] [CrossRef]
- Kumar, S.; Stecher, G.; Li, M.; Knyaz, C.; Tamura, K. MEGA X: Molecular Evolutionary Genetics Analysis across Computing Platforms. Mol. Biol. Evol. 2018, 35, 1547–1549. [Google Scholar] [CrossRef] [PubMed]
- Yamada, T.; Maeda, M.; Alshahni, M.M.; Tanaka, R.; Yaguchi, T.; Bontems, O.; Salamin, K.; Fratti, M.; Monod, M. Terbinafine resistance of Trichophyton clinical isolates caused by specific point mutations in the squalene epoxidase gene. Antimicrob. Agents Chemother. 2017, 61, e00115-17. [Google Scholar] [CrossRef] [PubMed]
- Mock, M.; Monod, M.; Baudraz-Rosselet, F.; Panizzon, R.G. Tinea capitis dermatophytes: Susceptibility to antifungal drugs tested in vitro and in vivo. Dermatology (Basel) 1998, 197, 361–367. [Google Scholar] [CrossRef] [PubMed]
- Laurent, A.; Monod, M. Production of Trichophyton rubrum microspores in large quantities and its application to evaluate amorolfine/azole compound interactions in vitro. Mycoses 2017, 60, 581–586. [Google Scholar] [CrossRef]
- Ebert, A.; Monod, M.; Salamin, K.; Burmester, A.; Uhrlaß, S.; Wiegand, C.; Hipler, U.-C.; Krüger, C.; Koch, D.; Wittig, F.; et al. Alarming India-wide phenomenon of antifungal resistance in dermatophytes: A multicentre study. Mycoses 2020, 63, 717–728. [Google Scholar] [CrossRef]
- Burmester, A.; Hipler, U.-C.; Hensche, R.; Elsner, P.; Wiegand, C. Point mutations in the squalene epoxidase gene of Indian ITS genotype VIII T. mentagrophytes identified after DNA isolation from infected scales. Med. Mycol. Case Rep. 2019, 26, 23–24. [Google Scholar] [CrossRef]
- Süß, A.; Uhrlaß, S.; Verma, S.B.; Ludes, A.; Monod, M.; Krüger, C.; Nenoff, P. Extensive tinea corporis due to a terbinafine resistant Trichophyton mentagrophytes isolate of the ‘Indian genotype’ in a young infant from Bahrain in Germany. Hautarzt 2019, 70, 888–896. [Google Scholar] [CrossRef]
- Nenoff, P.; Verma, S.B.; Vasani, R.; Burmester, A.; Hipler, U.-C.; Wittig, F.; Krüger, C.; Nenoff, K.; Wiegand, C.; Saraswat, A.; et al. The current Indian epidemic of superficial dermatophytosis due to Trichophyton mentagrophytes—A molecular study. Mycoses 2019, 62, 336–356. [Google Scholar] [CrossRef]
- Pathania, S.; Rudramurthy, S.M.; Narang, T.; Saikia, U.N.; Dogra, S. A prospective study of the epidemiological and clinical patterns of recurrent dermatophytosis at a tertiary care hospital in India. Indian J. Dermatol. Venereol. Leprol. 2018, 84, 678–684. [Google Scholar] [CrossRef]
- Rezaei-Matehkolaei, A.; Rafiei, A.; Makimura, K.; Gräser, Y.; Gharghani, M.; Sadeghi-Nejad, B. Epidemiological aspects of dermatophytosis in Khuzestan, southwestern Iran, an Update. Mycopathologia 2016, 181, 547–553. [Google Scholar] [CrossRef]
- Taghipour, S.; Pchelin, I.M.; Zarei-Mahmoudabadi, A.; Ansari, S.; Katiraei, F.; Rafiei, A.; Shokohi, T.; Abastabar, M.; Taraskina, A.E.; Kermani, F.; et al. Trichophyton mentagrophytes and T. interdigitale genotypes are associated with particular geographic areas and clinical manifestations. Mycoses 2019, 69, 1084–1091. [Google Scholar] [CrossRef] [PubMed]
- Nenoff, P.; Herrmann, J.; Gräser, Y. Trichophyton mentagrophytes sive interdigitale? A dermatophyte in the course of time. J. Dtsch. Dermatol. Ges. 2007, 5, 198–202. [Google Scholar] [CrossRef] [PubMed]
- Nenoff, P.; Krüger, C.; Schaller, J.; Ginter-Hanselmayer, G.; Schulte-Beerbühl, R.; Tietz, H.-J. Mycology-an update. Part 2: Dermatomycoses: Clinical picture and diagnostics. J. Dtsch. Dermatol. Ges. 2014, 12, 749–777. [Google Scholar] [CrossRef] [PubMed]
- Nenoff, P.; Verma, S.B.; Uhrlaß, S.; Burmester, A.; Gräser, Y. A clarion call for preventing taxonomical errors of dermatophytes using the example of the novel Trichophyton mentagrophytes genotype VIII uniformly isolated in the Indian epidemic of superficial dermatophytosis. Mycoses 2019, 62, 6–10. [Google Scholar] [CrossRef]
- Pchelin, I.M.; Azarov, D.V.; Churina, M.A.; Scherbak, S.G.; Apalko, S.V.; Vasilyeva, N.V.; Taraskina, A.E. Species boundaries in the Trichophyton mentagrophytes/T. interdigitale species complex. Med. Mycol. 2019, 57, 781–789. [Google Scholar] [CrossRef]
- Shamsizadeh, F.; Pchelin, I.M.; Makimura, K.; Alshahni, M.M.; Satoh, K.; Katiraee, F.; Ahmadi, B.; Rezaei-Matehhkolaei, A. DNA Topoisomerase 2 Gene Polymorphism in Dermatophytes. Mycoses 2020. [Google Scholar] [CrossRef]
- De Hoog, G.S.; Dukik, K.; Monod, M.; Packeu, A.; Stubbe, D.; Hendrickx, M.; Kupsch, C.; Stielow, J.B.; Freeke, J.; Göker, M.; et al. Toward a novel multilocus phylogenetic taxonomy for the dermatophytes. Mycopathologia 2017, 182, 5–31. [Google Scholar] [CrossRef]
- Verma, S.; Vasani, R.; Gupta, S. Involvement of little discussed anatomical locations in superficial dermatophytosis sundry observations and musings. Indian Dermatol. Online J. 2020, 11, 419–424. [Google Scholar] [CrossRef]
- Taghipour, S.; Shamsizadeh, F.; Pchelin, I.M.; Rezaei-Matehhkolaei, A.; Zarei Mahmoudabadi, A.; Valadan, R.; Ansari, S.; Katiraee, F.; Pakshir, K.; Zomorodian, K.; et al. Emergence of terbinafine resistant Trichophyton mentagrophytes in Iran, harboring mutations in the squalene epoxidase (SQLE) gene. Infect. Drug Resist. 2020, 13, 845–850. [Google Scholar] [CrossRef]
- Burmester, A.; Hipler, U.-C.; Uhrlaß, S.; Nenoff, P.; Singal, A.; Verma, S.B.; Elsner, P.; Wiegand, C. Indian T. mentagrophytes squalene epoxidase erg1 double mutants show high proportion of combined fluconazole and terbinafine resistance. Mycoses 2020. [Google Scholar] [CrossRef]
- Kano, R.; Kimura, U.; Kakurai, M.; Hiruma, J.; Kamata, H.; Suga, Y.; Harada, K. Trichophyton indotineae sp. nov.: A new highly terbinafine-resistant anthropophilic dermatophyte species. Mycopathologia 2020. [Google Scholar] [CrossRef]
- Järv, H.; Uhrlaß, S.; Simkin, T.; Nenoff, P.; Alvarado Ramirez, E.; Chryssanthou, E.; Monod, M. Terbinafine resistant Trichophyton mentagrophytes genotype VIII, Indian type, isolated in Finland. J. Fungi. 2019, 5, 117. [Google Scholar]
- Uhrlass, S.; Sithach, M.; Koch, D.; Wittig, F.; Muetze, H.; Krueger, C.; Nenoff, P. Trichophyton mentagrophytes—A new genotype in Cambodia. J. Fungi. 2019, 5, 460. [Google Scholar]
- Singh, A.; Masih, A.; Khurana, A.; Singh, P.K.; Gupta, M.; Hagen, F.; Meis, J.F.; Chowdhary, A. High terbinafine resistance in Trichophyton interdigitale isolates in Delhi, India harbouring mutations in the Squalene epoxidase (SQLE) gene. Mycoses 2018, 61, 477–484. [Google Scholar] [CrossRef]
- Khurana, A.; Sardana, K.; Chowdhary, A. Antifungal resistance in dermatophytes: Recent trends and therapeutic implications. Fungal. Genet. Biol. 2019, 132, 103255. [Google Scholar] [CrossRef] [PubMed]
- Khurana, A.; Masih, A.; Chowdhary, A.; Sardana, K.; Borker, S.; Gupta, A.; Gautam, R.K.; Sharma, P.K.; Jain, D. Correlation of in vitro susceptibility based on MICs and SQLE mutations with clinical response to terbinafine in patients with tinea corporis/cruris. Antimicrob. Agents Chemother. 2018, 62. [Google Scholar] [CrossRef]
- Shaw, D.; Singh, S.; Dogra, S.; Jayaraman, J.; Bhat, R.; Panda, S.; Chakrabarti, A.; Anjum, N.; Chowdappa, A.; Nagamoti, M.; et al. MIC and upper limit of wild-type distribution for 13 antifungal agents against a Trichophyton mentagrophytes-Trichophyton interdigitale complex of indian origin. Antimicrob. Agents Chemother. 2020, 64. [Google Scholar] [CrossRef]

| Strain Number | Collection No. DSMZ | Gender | Age in Years/ Months | Pathology | Additional Information/ Remarks | MIC Terbinafine [µg/mL] | Drug Resistance to Terbinafine | Amino Acid Substitution within the Squalene Epoxidase | Codon Change in SQLE | MIC itraconazole [µg/mL] | Drug Resistance to Itraconazole | MIC Voriconazole [µg/mL] | Drug Resistance to Voriconazole | GenBank Accession Number ITS Gene | GenBank Accession Number TEF1-α Gene (NCBI) | GenBank Accession Number SQLE Gene (NCBI) | Sample Date | |
|---|---|---|---|---|---|---|---|---|---|---|---|---|---|---|---|---|---|---|
| 1 | 214677/16 | DSM 108903 | f | 35 | Tinea pedis | Indian | 0.2 | resistant | Phe397Leu | TTC → CTC | 0.06 | sensitive | 0.03 | sensitive | MT330252 | MT340499 | MT700499 | 2016 |
| 2 | 216377/17 | DSM 108902 | f | 29 | Tinea | Foreigners | 0.2 | resistant | Phe397Leu | TTC → CTC | 0.06 | sensitive | 0.03 | sensitive | MT330249 | MT340500 | MT700500 | 2017 |
| 3 | 211542/18 | DSM 108901 | m | 19 | Tinea corporis | Asylum office Herford | 8 | resistant | Phe397Leu | TTC → CTC | 0.087 | sensitive | 0.088 | sensitive | MT330250 | MT340501 | MT700501 | 2018 |
| 4 | 211564/18 | DSM 108900 | f | 30 | Tinea unguium et corporis | Indian | <0.2 | sensitive | Ala448Thr | GCT → ACT | 0.067 | sensitive | 0.088 | sensitive | MT330248 | MT340502 | MT700502 | 2018 |
| 5 | 218160/18 | DSM 108899 | m | 35 | Tinea corporis et cruris | Indian | <0.2 | sensitive | wild type | - | 0.125 | sensitive | 0.03 | sensitive | MT330253 | MT340503 | MT700503 | 2018 |
| 6 | 218360/18 | DSM 108898 | f | 25 | Tinea corporis | married couple on a pilgrimage in Saudi Arabia | <0.2 | sensitive | Ala448Thr | GCT → ACT | 0.5 | resistant | 0.5 | resistant | MT330255 | MT340504 | MT700504 | 2018 |
| 7 | 218691/18 | DSM 108897 | m | 58 | Tinea faciei | Visit India | 8 | resistant | Phe397Leu | TTC → CTC | 0.125 | sensitive | 0.03 | sensitive | MT330254 | MT340505 | MT700505 | 2018 |
| 8 | 901538/18 | DSM 108896 | m | 4 | Tinea corporis | German name | <0.2 | sensitive | Ala448Thr | GCT → ACT | 0.25 | sensitiv | 0.25 | resistant | MT330251 | MT340506 | MT700506 | 2018 |
| 9 | 200618/19 | DSM 109024 | f | 6 months | Tinea corporis | Family came from Bahrain to visit Germany | 0.2 | resistant | Phe397Leu | TTC → TTA | not applied | not applied | MT330285 | MT345568 | MT700507 | 2019 | ||
| 10 | 202953/19 | DSM 109747 | m | 27 | Tinea | Libyan, for three years in Germany, German girlfriend also affected | 8 | resistant | Phe397Leu | TTC→CTC | 0.5 | resistant | 0.25 | resistant | MT330284 | MT340507 | MT700508 | 2019 |
| 11 | 203513/19 | DSM 109748 | f | 25 | Tinea cruris et inguinalis | Pakistani | <0.2 | sensitive | wild type | - | 0.0312 | sensitive | 0.0312 | sensitive | MT330280 | MT340508 | MT700509 | 2019 |
| 12 | 600174/19 | DSM 109749 | f | 34 | Tinea corporis | Indian, was in India when the skin symptoms started | <0.2 | sensitive | Ala448Thr | GCT → ACT | 0.125 | sensitive | 0.0312 | sensitive | MT330279 | MT340517 | MT700510 | 2019 |
| 13 | 205666/19 | DSM 109751 | m | 32 | Tinea cruris | Iraqi couple (see no. 14) | <0.2 | sensitive | Ala448Thr | GCT → ACT | 0.125 | sensitive | 0.125 | sensitive | MT330281 | MT340516 | MT700511 | 2019 |
| 14 | 205667/19 | DSM 109750 | f | 31 | Tinea corporis | Iraqi couple (see no. 13) | <0.2 | sensitive | Ala448Thr | GCT → ACT | 0.5 | resistant | 0.5 | resistant | MT330283 | MT340515 | MT700512 | 2019 |
| 15 | 208737/19 | DSM 110678 | f | 29 | Tinea corporis | Indian name | 8 | resistant | Phe397Leu | TTC → TTA | not applied | - | not applied | - | MT328783 | MT340514 | MT700513 | 2019 |
| 16 | 209934/19 | DSM 110677 | m | 28 | Tinea corporis gluteal | Indian name | <0.2 | sensitive | Ala448Thr | GCT → ACT | not applied | - | not applied | - | MT330278 | MT340513 | MT700514 | 2019 |
| 17 | 600231/19 | DSM 110676 | m | 40 | Tinea corporis | Family, large plaques | 16 | resistant | Leu393Phe | TTA → TTC | not applied | - | not applied | - | MT330282 | MT340512 | MT700515 | 2019 |
| 18 | 214174/19 | DSM 110675 | m | 37 | Tinea faciei and corporis: cheeks, neck, forehead, and ear helix | German | 8 | resistant | Phe397Leu Ala448Thr | TTC → CTC GCT → ACT | not applied | - | not applied | - | MT330289 | MT340511 | MT700516 | 2019 |
| 19 | 216532/19 | DSM 110674 | m | 27 | Tinea corporis | Indian | <0.2 | sensitive | Ala448Thr | GCT → ACT | not applied | - | not applied | - | MT330288 | MT340510 | MT700517 | 2019 |
| 20 | 217201/19 | DSM 110673 | m | 24 | Tinea corporis | Indian | <0.2 | sensitive | Val444 Ile Ala448Thr | GTA → ATAGCT → ACT | not applied | - | not applied | - | MT330286 | MT340509 | MT700518 | 2019 |
| 21 | 218676/19 | - | m | 20 | Tinea corporis | Foreigner | <0.2 | sensitive | wild type | - | not applied | - | not applied | - | MT330256 | MT340518 | MT700519 | 2019 |
| 22 | 219238/19 | - | f | 27 | Tinea corporis | Pakistani | <0.2 | sensitive | wild type | - | not applied | - | not applied | - | MT330290 | MT340519 | MT700520 | 2019 |
| 23 | 600380/19 | - | - | Tinea | Indian | <0.2 | sensitive | wild type | - | not applied | - | not applied | - | MT330291 | MT340520 | MT700521 | 2019 | |
| 24 | 220575/19 | - | f | 24 | Tinea corporis gluteal | Student from Bangladesh | <0.2 | sensitive | wild type | - | not applied | - | not applied | - | MT330287 | MT340521 | MT700522 | 2019 |
| 25 | 600002/20 | - | m | Tinea cruris | German patient with stay in Thailand and India | 16 | resistant | Phe397Leu | TTC → CTC | not applied | - | not applied | - | MT333227 | MT340522 | MT700523 | 2020 | |
| 26 | 101549/20 | - | m | 30 | Tinea | Foreigner | 16 | resistant | Phe397Leu Ala448Thr | TTC → CTCGCT → ACT | not applied | - | not applied | - | MT333225 | MT340523 | MT700524 | 2020 |
| 27 | 200874/20 | - | m | 27 | Tinea corporis et manum | Foreigner | <0.2 | sensitive | wild type | not applied | - | not applied | - | MT333228 | MT345569 | MT700525 | 2020 | |
| 28 | 900138/20 | - | m | 51 | Tinea corporis | Foreigner | 16 | resistant | Phe397Leu | TTC → CTC | not applied | - | not applied | - | MT333226 | MT340524 | MT700526 | 2020 |
| 29 | 204532/20 | - | f | 23 | Tinea corporis | Originating and migrating for studying from Bangladesh, her father also affected. She was pretreated in her home country by oral voriconazole, without success. | 0.2 | resistant | Phe397Leu | TTC → CTC | not applied | - | not applied | - | MT333242 | MT340525 | MT700527 | 2020 |
| Species/Genotype | Strain | Collection | Accession No. NCBI ITS | Accession No. NCBI TEF1-α |
|---|---|---|---|---|
| T. interdigitale ITS genotype I | 208223/17 | DSM 108620 | MK447595 | MK460538 |
| T. interdigitale ITS genotype I deposited in the NCBI as T. interdigitale | Isolate 2 | KC595991 | ||
| T. interdigitale ITS genotype II | 200070/17 | DSM 108621 | MK447596 | MK460539 |
| T. interdigitale ITS genotype II deposited in the NCBI as T. interdigitale | RCPF-1301 | KP308373 | ||
| T. interdigitale ITS genotype II deposited in the NCBI as T. interdigitale | CBS 475.93 | MF926357 | ||
| T. interdigitale ITS genotype II deposited in the NCBI as T. interdigitale | CBS 428.63 | NR_144900 | ||
| T. interdigitale ITS genotype II deposited in the NCBI as T. mentagrophytes | CBS 647.73 | KT155955 | ||
| T. mentagrophytes deposited in the NCBI as T. mentagrophytes | CBS 102.68 | KM678062 | ||
| T. interdigitale ITS genotype II * | 212063/17 | DSM 108905 | MK630684 | MK751367 |
| T. interdigitale ITS genotype II * | 250016/18 | MN886818 | MN886231 | |
| T. mentagrophytes | CBS 116916 | KM678130 | ||
| T. interdigitale | CBS 130940 | KM678173 | ||
| T. mentagrophytes ITS genotype III | 217704/15 | DSM 108630 | MK450325 | MK460541 |
| T. mentagrophytes ITS genotype III | 200002/16 | DSM 103451 | KX866689 | MK460540 |
| ITS genotype III deposited in the NCBI as T. cf. mentagrophytes | ATCC 60612 | KJ606099 | ||
| T. mentagrophytes ITS genotype III deposited in the NCBI as T. mentagrophytes | RCPF-1207 | KT253559 | ||
| T. mentagrophytes ITS genotype III * | 217907/15 | DSM 108628 | MK447605 | MK460542 |
| T. mentagrophytes ITS genotype III * | 218893/16 | DSM 108629 | MK447604 | MK460543 |
| T. mentagrophytes ITS genotype III * | 900120/17 | DSM 108632 | MK447606 | MK460544 |
| T. mentagrophytes ITS genotype III * deposited in the NCBI as T. interdigitale | CZE 4473 | LN736306 | ||
| T. mentagrophytes ITS genotype IV | 200602/17 | DSM 108631 | MK447607 | MK467447 |
| T. mentagrophytes ITS genotype IV | 200617/17 | DSM 108627 | MK447608 | MK467446 |
| T. mentagrophytes ITS genotype IV | 204543/17 | DSM 108626 | MK447609 | MK467445 |
| T. mentagrophytes ITS genotype IV deposited in the NCBI as T. mentagrophytes | CBS 304.38 | MF926360 | ||
| T. mentagrophytes ITS genotype IV deposited in the NCBI as T. interdigitale | SJEK 4836 | FM986773 | ||
| T. mentagrophytes ITS genotype V deposited in the NCBI as T. cf. mentagrophytes | ATCC 46950 | KJ606098 | ||
| T. mentagrophytes ITS genotype V | 600014/20 | MT374268 | MT375511 | |
| T. mentagrophytes ITS genotype V | 600024/20 | MT374269 | MT375512 | |
| T. mentagrophytes ITS genotype V | 600184/19 | MT374259 | MT375508 | |
| T. mentagrophytes ITS genotype V | 600197/19 | MT374258 | MT375509 | |
| T. mentagrophytes ITS genotype V | 600316/19 | MT374257 | MT375510 | |
| T. mentagrophytes ITS genotype VI deposited in the NCBI as T. mentagrophytes | D15P161/17 | MK722518 | - | |
| T. mentagrophytes ITS genotype VII | 210363/16 | DSM 108625 | MK450323 | MK467450 |
| T. mentagrophytes ITS genotype VII | 218904/16 | DSM 108622 | MK450322 | MK467448 |
| T. mentagrophytes ITS genotype VII | 200128/17 | DSM 108623 | MK447611 | MK460545 |
| T. mentagrophytes ITS genotype VII | 215003/16 | DSM 108624 | MK450324 | MK467449 |
| T. mentagrophytes ITS genotype VII deposited in the NCBI as T. mentagrophytes | NBRC 5809 | JN134101 | ||
| T. mentagrophytes ITS genotype VIII | 211509/17 | DSM 107597 | MH791420 | MH802491 |
| T. mentagrophytes ITS genotype VIII | 200095/18 | DSM 107602 | MH791425 | MH802496 |
| T. mentagrophytes ITS genotype VIII deposited in the NCBI as T. interdigitale | VPCI 390/P/17 | - | MH990852 | |
| T. mentagrophytes ITS genotype IX | 214691/17 | DSM 108357 | MK447613 | MK467444 |
| T. mentagrophytes ITS genotype XXV | 218292/17 | - | MN886815 | MN886229 |
| T. mentagrophytes ITS genotype XXV | 201341/18 | - | MN886816 | MN886230 |
| T. quinckeanum | 218251/16 | |||
| T. quinckeanum | 210314/16 | |||
| T. quinckeanum | ATCC 32457 | KJ606088 | ||
| T. quinckeanum | 216686/15 | KY680503 | KY680502 |
© 2020 by the authors. Licensee MDPI, Basel, Switzerland. This article is an open access article distributed under the terms and conditions of the Creative Commons Attribution (CC BY) license (http://creativecommons.org/licenses/by/4.0/).
Share and Cite
Nenoff, P.; Verma, S.B.; Ebert, A.; Süß, A.; Fischer, E.; Auerswald, E.; Dessoi, S.; Hofmann, W.; Schmidt, S.; Neubert, K.; et al. Spread of Terbinafine-Resistant Trichophyton mentagrophytes Type VIII (India) in Germany–“The Tip of the Iceberg?”. J. Fungi 2020, 6, 207. https://doi.org/10.3390/jof6040207
Nenoff P, Verma SB, Ebert A, Süß A, Fischer E, Auerswald E, Dessoi S, Hofmann W, Schmidt S, Neubert K, et al. Spread of Terbinafine-Resistant Trichophyton mentagrophytes Type VIII (India) in Germany–“The Tip of the Iceberg?”. Journal of Fungi. 2020; 6(4):207. https://doi.org/10.3390/jof6040207
Chicago/Turabian StyleNenoff, Pietro, Shyam B. Verma, Andreas Ebert, Anke Süß, Eleni Fischer, Elke Auerswald, Stephanie Dessoi, Wencke Hofmann, Simone Schmidt, Kathrin Neubert, and et al. 2020. "Spread of Terbinafine-Resistant Trichophyton mentagrophytes Type VIII (India) in Germany–“The Tip of the Iceberg?”" Journal of Fungi 6, no. 4: 207. https://doi.org/10.3390/jof6040207
APA StyleNenoff, P., Verma, S. B., Ebert, A., Süß, A., Fischer, E., Auerswald, E., Dessoi, S., Hofmann, W., Schmidt, S., Neubert, K., Renner, R., Sohl, S., Hradetzky, U., Krusche, U., Wenzel, H.-C., Staginnus, A., Schaller, J., Müller, V., Tauer, C., ... Uhrlaß, S. (2020). Spread of Terbinafine-Resistant Trichophyton mentagrophytes Type VIII (India) in Germany–“The Tip of the Iceberg?”. Journal of Fungi, 6(4), 207. https://doi.org/10.3390/jof6040207

